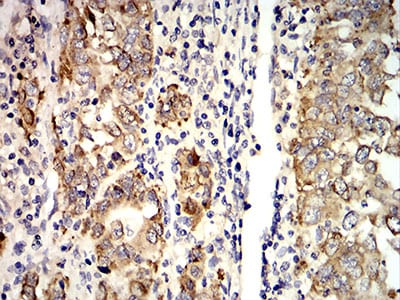

-
分类: 科研抗体货号: 31062别名: LKLF应用: WB反应种属: Human,Mouse
-
分类: 科研抗体货号: 31077别名: AG2; GOB-4; HAG-2; XAG-2; PDIA17; HEL-S-116应用: IF,FCM反应种属: Human
-
分类: 科研抗体货号: 31091别名: ERR1; ERRa; ESRL1; NR3B1; ERRalpha应用: WB,FCM反应种属: Human,Rat
-
分类: 科研抗体货号: 31090别名:应用: IF,FCM反应种属: Human
-
分类: 科研抗体货号: 31085别名: PZF; DMS-8; DSM-8; FKSG11; ZFP-91; ZNF757应用: WB,IHC,IF,FCM反应种属: Human
-
分类: 科研抗体货号: 31076别名: AG2; GOB-4; HAG-2; XAG-2; PDIA17; HEL-S-116应用: IHC,FCM反应种属: Human
-
分类: 科研抗体货号: 31089别名:应用: IHC,IF,FCM反应种属: Human
-
分类: 科研抗体货号: 31075别名: TDT应用: WB,FCM反应种属: Human,Rat
-
分类: 科研抗体货号: 31084别名: GH; GHN; GH-N; GHB5; hGH-N; IGHD1B应用: FCM反应种属: Human
-
分类: 科研抗体货号: 31088别名: MI; WS2; CMM8; WS2A; bHLHe32应用: WB,FCM反应种属: Human

鄂公网安备42018502007531号
鄂公网安备42018502007531号

